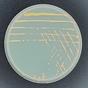

| 排行 | 公众号 | 上榜次数 | 预估粉丝 | 头条平均阅读 | 原创文章占比 | 西瓜指数 | 操作 |
|---|---|---|---|---|---|---|---|
| 1 |
 景观大数据LandBD
景观大数据LandBD
|
289 | 46977 | 47685 | 33.33 |
240.1 | 详情 |
| 2 |
 氢消费HQingXiaoFei
氢消费HQingXiaoFei
|
544 | 57323 | 39018 | 100 |
196.5 | 详情 |
| 3 |
 深响deep-echo
深响deep-echo
|
491 | 419938 | 29474 | 100 |
148.4 | 详情 |
| 4 |
 芯东西aichip001
芯东西aichip001
|
463 | 128581 | 16168 | 50 |
140.6 | 详情 |
| 5 |
 泡泡范儿wanyishudongchaoliu
泡泡范儿wanyishudongchaoliu
|
3 | 33968 | 24853 | 100 |
125.3 | 详情 |
| 6 |
 液压贼船yyzc80
液压贼船yyzc80
|
229 | 25650 | 24556 | 50 |
123.6 | 详情 |
| 7 |
 锦缎jinduan006
锦缎jinduan006
|
466 | 58001 | 22149 | 33.33 |
111.6 | 详情 |
| 8 |
 Super黄的念想autojinrong
Super黄的念想autojinrong
|
49 | 53121 | 21633 | 100 |
109.0 | 详情 |
| 9 |
吾爱微生物DLMU2020
吾爱微生物DLMU2020
|
32 | 18122 | 16862 | 100 |
84.9 | 详情 |
| 10 |
 代码随想录code_thinking
代码随想录code_thinking
|
1098 | 308894 | 16649 | 50 |
83.8 | 详情 |
| 11 |
 南瑞人nari-ren
南瑞人nari-ren
|
15 | 42840 | 16395 | 100 |
82.6 | 详情 |
| 12 |
 工控教练xxdd703
工控教练xxdd703
|
225 | 67388 | 16377 | 100 |
82.4 | 详情 |
| 13 |
 WSJ中文版WSJmagazinechina
WSJ中文版WSJmagazinechina
|
175 | 192046 | 16228 | 100 |
81.7 | 详情 |
| 14 |
 念水的咏叹调gh_201446574d90
念水的咏叹调gh_201446574d90
|
27 | 20925 | 16000 | 100 |
80.5 | 详情 |
| 15 |
 医学论文与统计分析medicalstat
医学论文与统计分析medicalstat
|
693 | 84435 | 15117 | 50 |
76.1 | 详情 |
| 16 |
 无相商业趋势wuxiangcj
无相商业趋势wuxiangcj
|
176 | 103968 | 14162 | 100 |
71.3 | 详情 |
| 17 |
 浪潮新消费lcxinxiaofei
浪潮新消费lcxinxiaofei
|
649 | 279327 | 12890 | 20 |
64.9 | 详情 |
| 18 |
 鲸商bizwhale
鲸商bizwhale
|
323 | 127353 | 12626 | 100 |
63.6 | 详情 |
| 19 |
 建筑科技BIMBOXBIM-BOX
建筑科技BIMBOXBIM-BOX
|
251 | 47064 | 12439 | 100 |
62.6 | 详情 |
| 20 |
 程序员的那些事iProgrammer
程序员的那些事iProgrammer
|
15 | 163435 | 12171 | 100 |
61.3 | 详情 |
验证微信账号
请使用注册的微信号扫一扫验证



 关注西瓜微信公众号
关注西瓜微信公众号